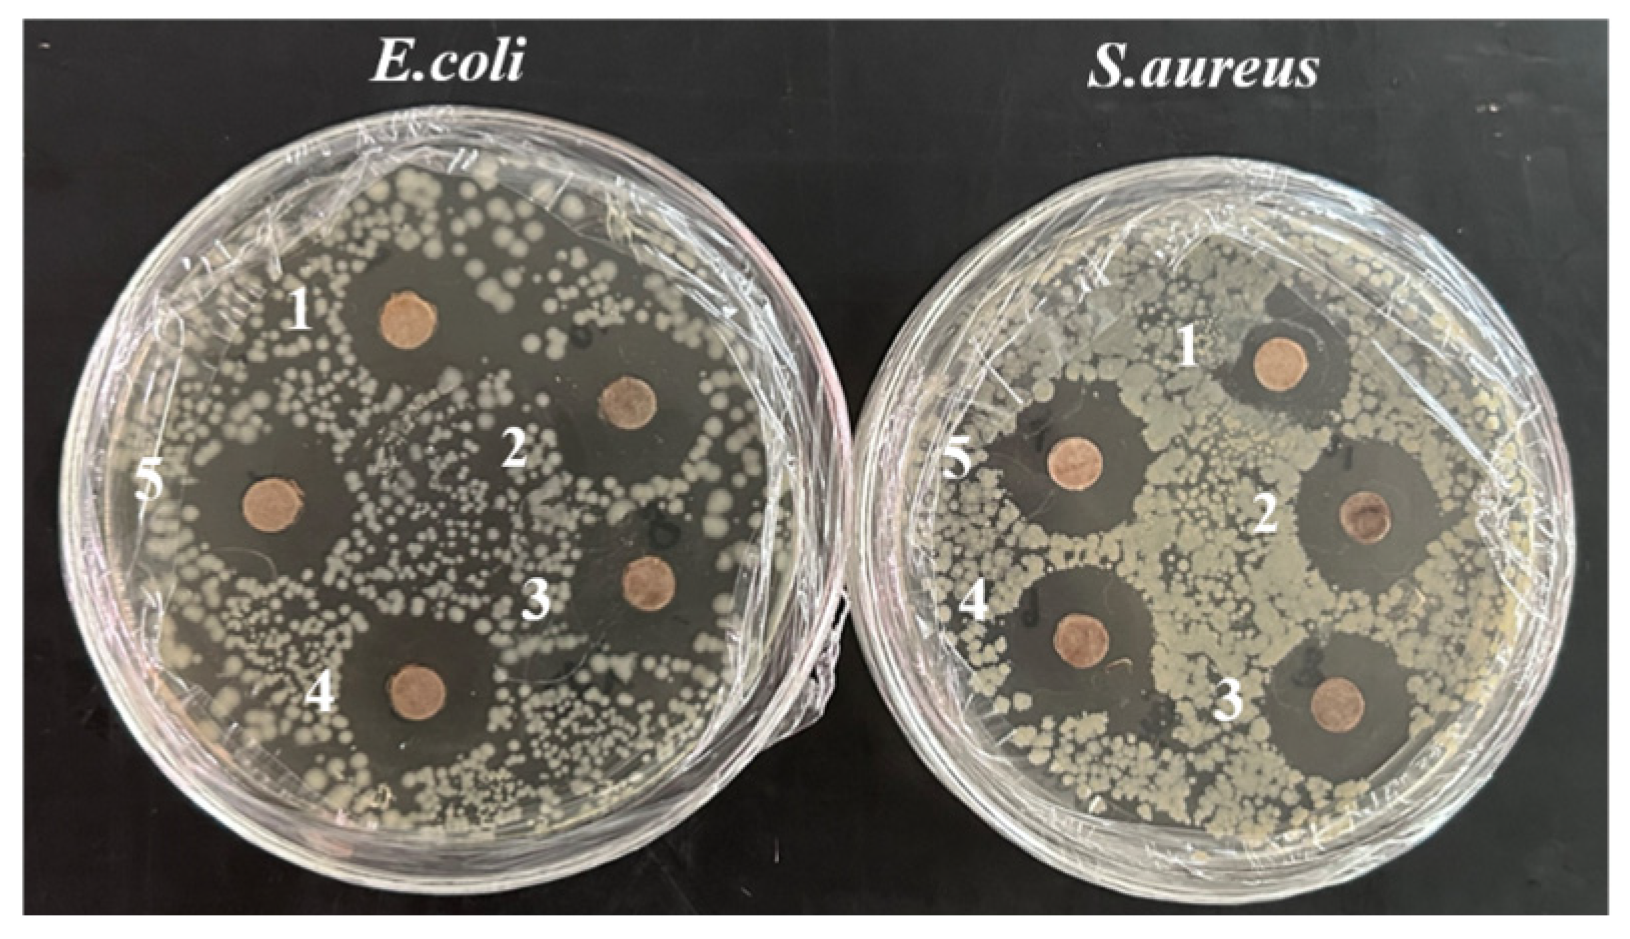
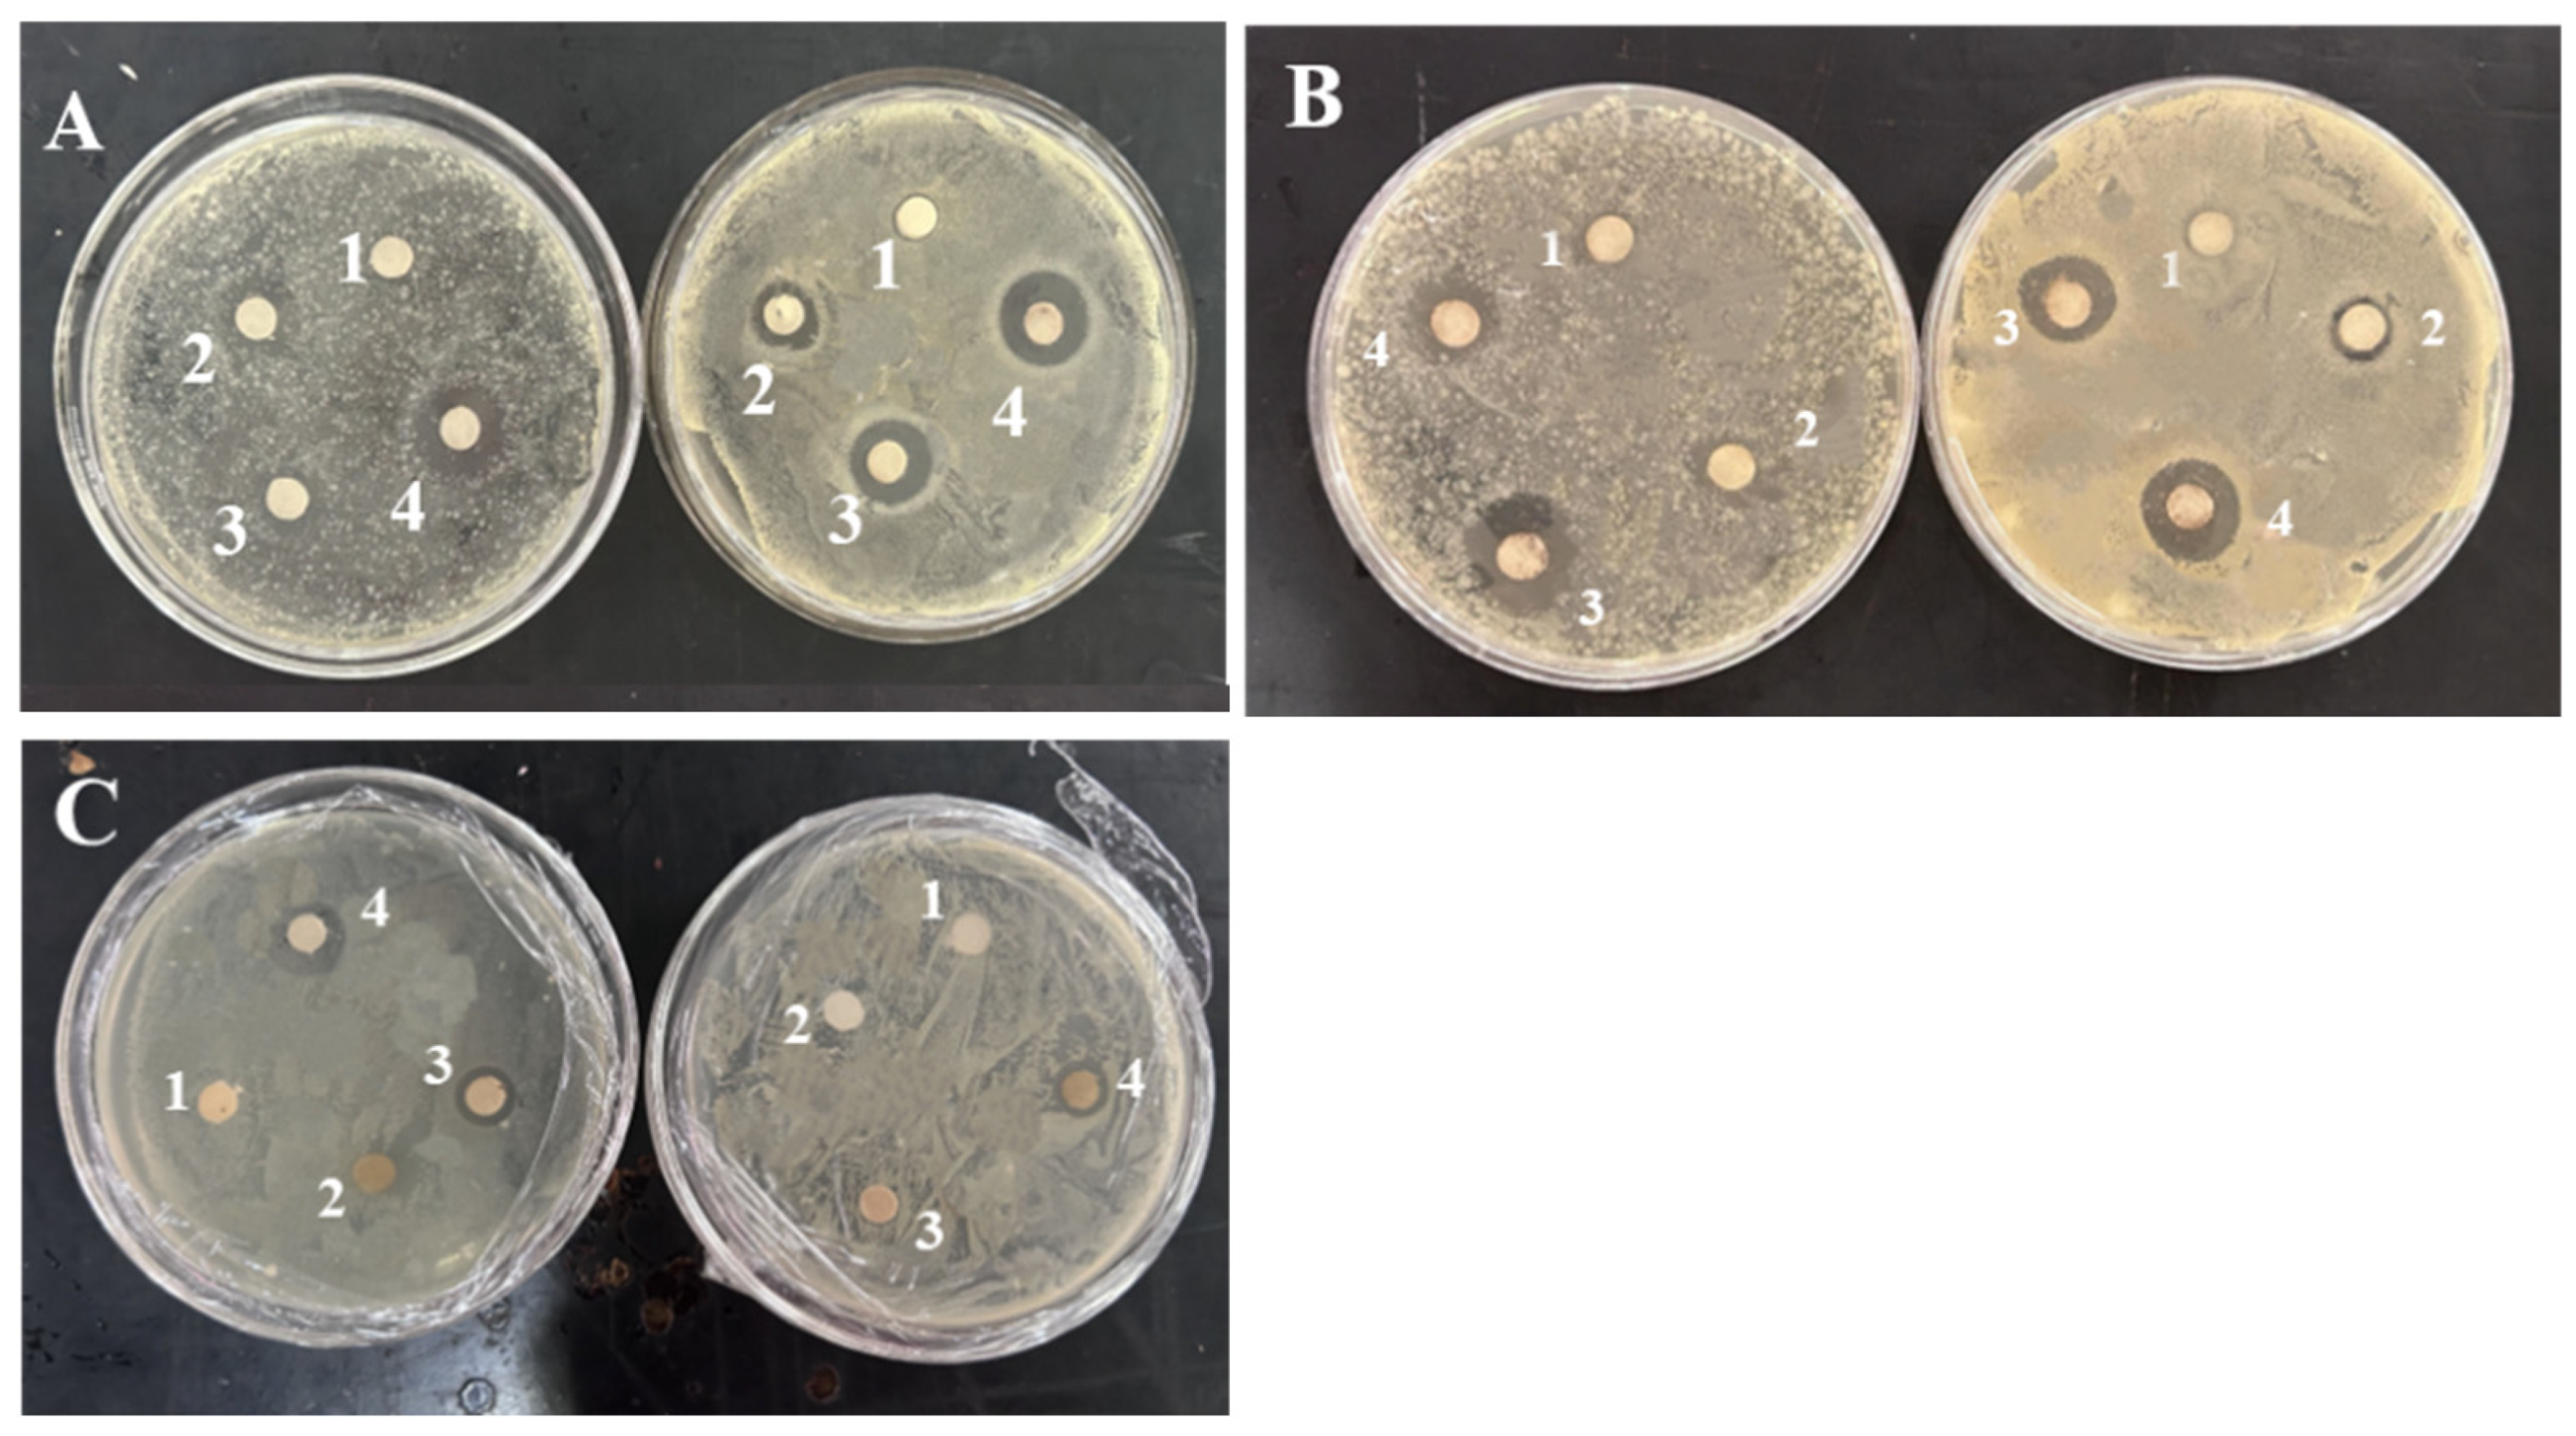

Green-Synthesized Silver Nanoparticle-Loaded Antimicrobial Films: Preparation, Characterization, and Food Preservation
Abstract
1. Introduction
2. Materials and Methods
2.1. Materials
2.2. Preparation and Characterization of Plant Extract
2.3. Synthesis and Characterization of AgNPs
2.3.1. Structural Characterization of AgNPs
2.3.2. Antimicrobial Activity of AgNPs
2.4. Preparation of Composite Films
2.5. Characterization of Composite Films
2.5.1. Antimicrobial Properties
2.5.2. Specific Migration Experiment
2.5.3. Molecular Dynamics Simulation
2.6. Application in Grape and Banana Preservation
3. Results and Discussion
3.1. Analysis of Plant Extract
3.2. Synthesis of AgNPs
3.2.1. Analysis of Box–Behnken Design
3.2.2. Microscopic Structure Analysis of AgNPs
3.2.3. Antimicrobial Activity of AgNPs
3.3. Measurement of Physical and Chemical Indexes of Composite Film
3.3.1. Structural Characterization of Composite Films
3.3.2. Mechanical Properties
3.3.3. Optical Property
3.3.4. Barrier Performance
3.4. Moisture Absorption
3.5. Antimicrobial Activity
3.6. Specific Migration Experiment
3.7. MD Results
3.8. Freshness Performance
4. Conclusions
Supplementary Materials
Author Contributions
Funding
Institutional Review Board Statement
Informed Consent Statement
Data Availability Statement
Conflicts of Interest
References
- Fahmy, H.M.; Salah, E.R.; Abu, S.E.; Gomaa, N.M.; AboElmagd, G.M.; Salem, S.A.; Elsayed, Z.A.; Edrees, A.; Shams-Eldin, E.; Shalan, A.E. Advances in nanotechnology and antibacterial properties of biodegradable food packaging materials. RSC Adv. 2020, 10, 20467–20484. [Google Scholar] [CrossRef] [PubMed]
- Wrona, M.; Nerín, C. Analytical approaches for analysis of safety of modern food packaging: A review. Molecules 2020, 25, 752. [Google Scholar] [CrossRef] [PubMed]
- Jiang, J.; Watowita, P.S.M.S.L.; Chen, R.; Shi, Y.; Geng, J.-T.; Takahashi, K.; Li, L.; Osako, K. Multilayer gelatin/myofibrillar films containing clove essential oil: Properties, protein-phenolic interactions, and migration of active compounds. Food Packag. Shelf 2022, 32, 100842. [Google Scholar] [CrossRef]
- Chen, Z.; Liu, R.; Wei, Y.; Li, B.; Luo, W.; Zhu, X.; Huang, C. A novel strategy to transform mango peel waste into useful product—Preparing antibacterial film containing tea polyphenols for chicken breast preservation. Food Sci. Technol. 2024, 197, 115933. [Google Scholar] [CrossRef]
- Emir, A.A.; Yildiz, E.; Kirtil, E. Peppermint oil-infused polylactic acid films: A novel approach for antimicrobial and biodegradable food packaging. Polym. Eng. Sci. 2024, 64, 2943–2955. [Google Scholar] [CrossRef]
- Ivanov, Y.; Godjevargova, T. Antimicrobial polymer films with grape seed and skin extracts for food packaging. Microorganisms 2024, 12, 1378. [Google Scholar] [CrossRef] [PubMed]
- Yang, P.; Song, Y.; Qi, H.; Li, L.; Xie, X. AIE-doped agar-based photodynamic sterilization film for antimicrobial food wrapping. LWT 2024, 202, 116330. [Google Scholar] [CrossRef]
- Srisaisap, M.; Boonserm, P. Anticancer efficacy of biosynthesized silver nanoparticles loaded with recombinant truncated parasporin-2 protein. Sci. Rep. 2024, 14, 15544. [Google Scholar] [CrossRef] [PubMed]
- Yang, D.; Liu, Q.; Gao, Y.; Wan, S.; Meng, F.; Weng, W.; Zhang, Y. Characterization of silver nanoparticles loaded chitosan/polyvinyl alcohol antibacterial films for food packaging. Food Hydrocoll. 2023, 136, 108305. [Google Scholar] [CrossRef]
- Zhai, W.; Wang, X.; Wang, Y.; Xu, C. Preparation of poly(vinyl alcohol)/nano-silver film and its effect on the freshness preservation of yellow-bone fish. Packag. Eng. 2020, 41, 44–50. [Google Scholar]
- Metwaly, F.M.; Moghazy, M.A.; Sheded, M.G.; Mohamed, A.A.A. Green synthesis of silver nanoparticles using leaf extract of the hydrophyte Persicaria senegalensis: Preparation and antioxidant activity. Inorg. Nano-Met. Chem. 2024, 55, 700–710. [Google Scholar] [CrossRef]
- Muhammad, R.; Mai, A.H.A.A.; Naveed, A.; Chan, Y.Y.; Basit, Z. Green synthesis and characterization of silver nanoparticles using Zingiber officinale extracts to investigate their antibacterial potential. Int. J. Nanomed. 2024, 19, 13319–13338. [Google Scholar] [CrossRef] [PubMed]
- Al Baloushi, K.S.Y.; Senthilkumar, A.; Kandhan, K.; Subramanian, R.; Kizhakkayil, J.; Ramachandran, T.; Shehab, S.; Kurup, S.S.; Alyafei, M.A.M.; Al Dhaheri, A.S.; et al. Green synthesis and characterization of silver nanoparticles using Moringa peregrina and their toxicity on MCF-7 and caco-2 human cancer cells. Int. J. Nanomed. 2024, 3891–3905. [Google Scholar] [CrossRef] [PubMed]
- Rocha, V.; Ferreira-Santos, P.; Genisheva, Z.; Coelho, E.; Neves, I.C.; Tavares, T. Environmental remediation promoted by silver nanoparticles biosynthesized by eucalyptus leaves extract. J. Water Process Eng. 2023, 56, 104431. [Google Scholar] [CrossRef]
- Liu, S.; Zhang, D.; Chen, W.; Wang, X.; Ji, H.; Fu, Y.; Lü, C. Synthesis, antibacterial activity and action mechanism of silver-based nanomaterials with thermosensitive polymer-decorated graphene oxide as a stable support. Mater. Today Commun. 2023, 36, 106598. [Google Scholar] [CrossRef]
- Zheng, H.; Tang, H.; Yang, C.; Chen, J.; Wang, L.; Dong, Q.; Shi, W.; Li, L.; Liu, Y. Evaluation of the slow-release polylactic acid/polyhydroxyalkanoates active film containing oregano essential oil on the quality and flavor of chilled pufferfish (Takifugu obscurus) fillets. Food Chem. 2022, 385, 132693. [Google Scholar] [CrossRef] [PubMed]
- Azevedo, V.M.; Dias, M.V.; de Siqueira Elias, H.H.; Fukushima, K.L.; Silva, E.K.; de Deus Souza Carneiro, J.; de Fátima Ferreira Soares, N.; Borges, S.V. Effect of whey protein isolate films incorporated with montmorillonite and citric acid on the preservation of fresh-cut apples. Food Res. Int. 2018, 107, 306–313. [Google Scholar] [CrossRef] [PubMed]
- Afra, E.; Narchin, P. Creating extended antimicrobial property in paper by means of Ag and nanohybrids of montmorillonite (MMT). Holzforschung 2017, 71, 445–454. [Google Scholar] [CrossRef]
- Yang, Y.; Zhou, B.; Yu, L.; Song, G.; Ge, J.; Du, R. Biosynthesis and characterization of antibacterial bacterial cellulose composite membrane composed of montmorillonite and exopolysaccharides. Int. J. Biol. Macromol. 2023, 253, 127477. [Google Scholar] [CrossRef] [PubMed]
- Huang, H.; Huang, C.; Xu, Y.; Zheng, D. Research progress on the application of biomass-enhanced polyvinyl alcohol in food packaging. Packag. Eng. 2020, 41, 109–116. [Google Scholar]
- Amaregouda, Y.; Kamanna, K.; Gasti, T. Fabrication of intelligent/active films based on chitosan/polyvinyl alcohol matrices containing Jacaranda cuspidifolia anthocyanin for real-time monitoring of fish freshness. Int. J. Biol. Macromol. 2022, 218, 799–815. [Google Scholar] [CrossRef] [PubMed]
- Narayanan, V.; Alam, M.; Ahmad, N.; Balakrishnan, S.B.; Ganesan, V.; Shanmugasundaram, E.; Rajagopal, B.; Thambusamy, S. Electrospun poly (vinyl alcohol) nanofibers incorporating caffeic acid/cyclodextrins through the supramolecular assembly for antibacterial activity. Spectrochim. Acta Part A Mol. Biomol. Spectrosc. 2021, 249, 119308. [Google Scholar] [CrossRef] [PubMed]
- Oun, A.A.; Shin, G.H.; Kim, J.T. Antimicrobial, antioxidant, and pH-sensitive polyvinyl alcohol/chitosan-based composite films with aronia extract, cellulose nanocrystals, and grapefruit seed extract. Int. J. Biol. Macromol. 2022, 213, 381–393. [Google Scholar] [CrossRef] [PubMed]
- Pham, B.T.; Duong, T.T.; Nguyen, T.T.; Van Nguyen, D.; Trinh, C.D.; Bach, L.G. Development of polyvinyl (alcohol)/D-glucose/agar/silver nanoparticles nanocomposite film as potential food packaging material. J. Polym. Res. 2021, 28, 410. [Google Scholar] [CrossRef]
- He, L.; Zhang, H.; Zhao, N.; Liao, L. A novel approach in biomedical engineering: The use of polyvinyl alcohol hydrogel encapsulating human umbilical cord mesenchymal stem cell-derived exosomes for enhanced osteogenic differentiation and angiogenesis in bone regeneration. Int. J. Biol. Macromol. 2024, 270, 132116. [Google Scholar] [CrossRef] [PubMed]
- Madivoli, E.S.; Kisato, J.; Gichuki, J.; Wangui, C.M.; Kimani, P.K.; Kareru, P.G. Antimicrobial and food barrier properties of polyvinyl alcohol–lactic acid food packaging films. Food Sci. Nutr. 2024, 9, 6563–6577. [Google Scholar] [CrossRef] [PubMed]
- Zhang, K.; Liu, Y.; Shi, X.; Zhang, R.; He, Y.; Zhang, H.; Wang, W. Application of polyvinyl alcohol/chitosan copolymer hydrogels in biomedicine: A review. Int. J. Biol. Macromol. 2023, 242, 125192. [Google Scholar] [CrossRef] [PubMed]
- Gautam, A.; Komal, P. Synthesis of Montmorillonite Clay/Poly(vinyl alcohol) Nanocomposites and their Mechanical Properties. J. Nanosci. Nanotechnol. 2019, 19, 8071–8077. [Google Scholar] [CrossRef] [PubMed]
- Lei, Y.; Mao, L.; Yao, J.; Zhu, H. Improved mechanical, antibacterial and UV barrier properties of catechol-functionalized chitosan/polyvinyl alcohol biodegradable composites for active food packaging. Carbohydr. Polym. 2021, 264, 117997. [Google Scholar] [CrossRef] [PubMed]
- Chen, C.; Zong, L.; Wang, J.; Xie, J. Microfibrillated cellulose reinforced starch/polyvinyl alcohol antimicrobial active films with controlled release behavior of cinnamaldehyde. Carbohydr. Polym. 2021, 272, 118448. [Google Scholar] [CrossRef] [PubMed]
- Chen, J.; Zheng, M.; Tan, K.B.; Lin, J.; Chen, M.; Zhu, Y. Polyvinyl alcohol/xanthan gum composite film with excellent food packaging, storage and biodegradation capability as potential environmentally-friendly alternative to commercial plastic bag. Int. J. Biol. Macromol. 2022, 212, 402–411. [Google Scholar] [CrossRef] [PubMed]
- Anghel, N.; Spiridon, I.; Dinu, M.V.; Vlad, S.; Pertea, M. Xanthan-Polyurethane conjugates: An efficient approach for drug delivery. Polymers 2024, 16, 1734. [Google Scholar] [CrossRef] [PubMed]
- Alomar, T.S.; AlMasoud, N.; Awad, M.A.; El-Tohamy, M.F.; Soliman, D.A. An eco-friendly plant-mediated synthesis of silver nanoparticles: Characterization, pharmaceutical and biomedical applications. Mater. Chem. Phys. 2020, 249, 123007. [Google Scholar] [CrossRef]
- Kora, A.J.; Mounika, J.; Jagadeeshwar, R. Rice leaf extract synthesized silver nanoparticles: An in vitro fungicidal evaluation against Rhizoctonia solani, the causative agent of sheath blight disease in rice. Fungal Biol. 2020, 124, 671–681. [Google Scholar] [CrossRef] [PubMed]
- Alkhulaifi, M.M.; Alshehri, J.H.; Alwehaibi, M.A.; Awad, M.A.; Al-Enazi, N.M.; Aldosari, N.S.; Hatamleh, A.A.; Abdel- Raouf, N. Green synthesis of silver nanoparticles using Citrus limon peels and evaluation of their antibacterial and cytotoxic properties. Saudi J. Biol. Sci. 2020, 27, 3434–3441. [Google Scholar] [CrossRef] [PubMed]
- Mani, M.; Harikrishnan, R.; Purushothaman, P.; Pavithra, S.; Rajkumar, P.; Kumaresan, S.; Al Farraj, D.A.; Elshikh, M.S.; Balasubramanian, B.; Kaviyarasu, K. Systematic green synthesis of silver oxide nanoparticles for antimicrobial activity. Environ. Res. 2021, 1, 494–503. [Google Scholar] [CrossRef] [PubMed]
- Rodrigues, F.A.M.; Dos Santos, S.B.F.; Lopes, M.M.D.A.; Guimarães, D.J.S.; de Oliveira Silva, E.; de Souza Filho, M.D.S.M.; Mattos, A.L.A.; Da Silva, L.M.R.; de Azeredo, H.M.C.; Ricardo, N.M.P.S. Antioxidant films and coatings based on starch and phenolics from Spondias purpurea L. Int. J. Biol. Macromol. 2021, 182, 354–365. [Google Scholar] [CrossRef] [PubMed]
- Ejaz, U.; Afzal, M.; Mazhar, M.; Riaz, M.; Ahmed, N.; Rizg, W.Y.; Alahmadi, A.A.; Badr, M.Y.; Mushtaq, R.Y.; Yean, C.Y. Characterization, synthesis, and biological activities of silver nanoparticles produced via green synthesis method using thymus vulgaris aqueous extract. Int. J. Nanomed. 2024, 19, 453–469. [Google Scholar] [CrossRef] [PubMed]
- Rakesh, B.; Srinatha, N.; Rudresh, K.K.J.; Madhu, A.; Suresh, K.M.R.; Praveen, N. Antibacterial activity and spectroscopic characteristics of silver nanoparticles synthesized via plant and in vitro leaf-derived callus extracts of Mucuna pruriens (L.) DC. S. Afr. J. Bot. 2022, 148, 251–258. [Google Scholar]
- Guerrero, D.S.; Bertani, R.P.; Ledesma, A.; Frías, M.D.L.A.; Romero, C.M.; Dávila Costa, J.S. Silver nanoparticles synthesized by the heavy metal resistant strain Amycolatopsis tucumanensis and its application in controlling red strip disease in sugarcane. Heliyon 2022, 8, e09472. [Google Scholar] [CrossRef] [PubMed]
- Miljković, M.; Lazić, V.; Davidović, S.; Milivojević, A.; Papan, J.; Fernandes, M.M.; Lanceros-Mendez, S.; Ahrenkiel, S.P.; Nedeljković, J.M. Selective antimicrobial performance of biosynthesized silver nanoparticles by horsetail extract against E. coli. J. Inorg. Organomet. Polym. Mater. 2020, 20, 2598–2607. [Google Scholar] [CrossRef]
- Khatun, H.; Alam, S.; Aziz, M.A.; Karim, M.R.; Rahman, M.H.; Rabbi, M.A.; Habib, M.R. Plant-assisted green preparation of silver nanoparticles using leaf extract of Dalbergia sissoo and their antioxidant, antibacterial and catalytic applications. Bioproc. Biosyst. Eng. 2024, 8, 1347–1362. [Google Scholar] [CrossRef] [PubMed]
- Moteriya, P.; Chanda, S. Synthesis and characterization of silver nanoparticles using Caesalpinia pulcherrima flower extract and assessment of their in vitro antimicrobial, antioxidant, cytotoxic, and genotoxic activities. Artif. Cells Nanomed. Biotechnol. 2017, 45, 1556–1567. [Google Scholar] [CrossRef] [PubMed]
- Akhter, M.S.; Rahman, M.A.; Ripon, R.K.; Mubarak, M.; Akter, M.; Mahbub, S.; Al Mamun, F.; Sikder, M.T. A systematic review on green synthesis of silver nanoparticles using plants extract and their bio-medical applications. Heliyon 2024, 11, e29766. [Google Scholar] [CrossRef] [PubMed]
- Aadil, K.R.; Mussatto, S.I.; Jha, H. Synthesis and characterization of silver nanoparticles loaded poly(vinyl alcohol)-lignin electrospun nanofibers and their antimicrobial activity. Int. J. Biol. Macromol. 2018, 120, 763–767. [Google Scholar] [CrossRef] [PubMed]
- Bindhu, M.R.; Umadevi, M.; Esmail, G.A.; Al-Dhabi, N.A.; Arasu, M.V. Green synthesis and characterization of silver nanoparticles from Moringa oleifera flower and assessment of antimicrobial and sensing properties. J. Photochem. Photobiol. B Biol. 2020, 205, 111836. [Google Scholar] [CrossRef] [PubMed]
- Algarni, A.; Fayomi, A.; Al Garalleh, H.; Afandi, A.; Brindhadevi, K.; Pugazhendhi, A. Nanofabrication synthesis and its role in antibacterial, anti-inflammatory, and anticoagulant activities of AgNPs synthesized by Mangifera indica bark extract. Environ. Res. 2023, 1, 115983. [Google Scholar] [CrossRef] [PubMed]
- Sobi, M.A.; Usha, D.; Umadevi, M.; Bindhu, M.R.; Sureshkumar, S.; Al-Dosary, M.A.; Alodaini, H.A.; Hatamleh, A.A. Size dependent antimicrobial activity of Boerhaavia diffusa leaf mediated silver nanoparticles. J. King Saud Univ.-Sci. 2022, 5, 102096. [Google Scholar] [CrossRef]
- Tran, D.D.; Nguyen, D.V.; Nguyen, M.D.; Phan, L.T.M.; Doan, B.T.; Lu, T.M.T.; Le Minh, H.; Pham, T.K.; Nguyen, D.H.; Hoang, M.N.; et al. Characterization and bioactivities of silver nanoparticles green synthesized from Vietnamese Ganoderma lucidum. Surf. Interfaces 2021, 27, 101453. [Google Scholar]
- Cyriac, V.; Molakalu Padre, S.; Ismayil; Sangam Chandrashekar, G.; Chavan, C.; Fakeerappa Bhajantri, R.; Murari, M.S. Tuning the ionic conductivity of flexible polyvinyl alcohol/sodium bromide polymer electrolyte films by incorporating silver nanoparticles for energy storage device applications. J. Appl. Polym. Sci. 2022, 139, 52525. [Google Scholar] [CrossRef]
- Mathew, S.; Snigdha, S.; Jyothis, M.; Radhakrishnan, E.K. Biodegradable and active nanocomposite pouches reinforced with silver nanoparticles for improved packaging of chicken sausages. Food Packag. Shelf 2019, 19, 155–166. [Google Scholar] [CrossRef]
- Yahia, R.; Owda, M.E.; Abou Zeid, R.E.; Abdelhai, F.; Gad, E.S.; Saleh, A.K.; El Gamil, H.Y. Synthesis and characterization of thermoplastic starch/PVA/cardanol oil composites loaded with in-situ silver nanoparticles. J. Appl. Polym. Sci. 2022, 139, 51511. [Google Scholar] [CrossRef]
- Li, S.; Wei, N.; Wei, J.; Fang, C.; Feng, T.; Liu, F.; Liu, X.; Wu, B. Curcumin and silver nanoparticles loaded antibacterial multifunctional pectin/gelatin films for food packaging applications. Int. J. Biol. Macromol. 2024, 266, 131248. [Google Scholar] [CrossRef] [PubMed]
- Hong, S.; Wang, L.; Rhim, J. Preparation and characterization of nanoclays-incorporated polyethylene/thermoplastic starch composite films with antimicrobial activity. Food Packag. Shelf 2022, 31, 100784. [Google Scholar] [CrossRef]
- Ding, J.; Hao, Y.; Liu, B.; Chen, Y.; Li, L. Development and application of poly (Lactic Acid)/Poly (Butylene Adipate-Co-Terephthalate)/Thermoplastic starch film containing salicylic acid for banana preservation. Foods 2023, 18, 3397. [Google Scholar] [CrossRef] [PubMed]
- Han, J.H.; Floros, J.D. Casting antimicrobial packaging films and measuring their physical properties and antimicrobial activity. J. Plast. Film. Sheeting 1997, 4, 287–298. [Google Scholar] [CrossRef]
- Srinivasa, P.C.; Ramesh, M.N.; Kumar, K.R.; Tharanathan, R.N. Properties and sorption studies of chitosan–polyvinyl alcohol blend films. Carbohydr. Polym. 2003, 4, 431–438. [Google Scholar] [CrossRef]

| Independent Variables | Low Level | Level |
|---|---|---|
| AgNO3 concentration (mMol/L) | 1.5 | 2 |
| Time (h) | 1.5 | 2 |
| Temperature (°C) | 60 | 75 |
| NO. | Name | Retention Time | Area |
|---|---|---|---|
| 1 | Myricitrin | 9.96 | 3.49 × 107 |
| 2 | Isoorientin | 11.56 | 1.40 × 107 |
| 3 | Astragalin | 11.56 | 1.40 × 107 |
| 4 | (-)-Epigallocatechin Gallate | 7.90 | 1.01 × 107 |
| 5 | Gallic acid | 2.43 | 9.32 × 106 |
| 6 | Carissic acid | 39.08 | 8.79 × 106 |
| 7 | Quinic acid | 0.88 | 5.19 × 106 |
| 8 | Asiatic acid | 30.28 | 4.64 × 106 |
| 9 | Monooctyl phthalate | 35.63 | 3.20 × 106 |
| 10 | Hederagenin | 34.94 | 2.81 × 106 |
| 11 | Corosolic acid | 34.94 | 2.81 × 106 |
| 12 | 20beta-Hydroxyursolic acid | 34.94 | 2.81 × 106 |
| 13 | Albigenic acid | 34.94 | 2.81 × 106 |
| 14 | 23-Hydroxy-3-oxocycloart-24-en-26-oic acid | 34.94 | 2.80 × 106 |
| 15 | Quercitrin | 11.63 | 2.29 × 106 |
| System | Concentration of AgNPs (mMol/L) | E. coli (mm) | S. aureus (mm) |
|---|---|---|---|
| 1 | 0.5 | 15.76 | 17.42 |
| 2 | 2 | 18.65 | 18.82 |
| 3 | 4 | 18.68 | 18.84 |
| 4 | 6 | 17.17 | 20.21 |
| 5 | 8 | 18.79 | 18.57 |
| Samples | L* | a* | b* | T280 (%) | T600 (%) |
|---|---|---|---|---|---|
| P | 92.04 ± 0.28 b | −1.55 ± 0.24 b | −4.36 ± 0.46 b | 59.45 ± 0.87 b | 90.36 ± 0.64 a |
| PA1 | 68.91 ± 0.79 a | 18.21 ± 0.41 a | 37.91 ± 0.39 a | 10.34 ± 0.36 a | 75.67 ± 0.36 a |
| PA2 | 65.62 ± 0.91 a | 19.38 ± 0.48 b | 39.07 ± 0.76 b | 9.97 ± 0.94 b | 71.49 ± 0.28 b |
| PA3 | 61.18 ± 0.27 c | 23.17 ± 0.11 a | 37.36 ± 0.47 c | 8.56 ± 0.27 c | 68.41 ± 0.47 a |
| PAM1 | 74.63 ± 0.39 a | 11.40 ± 0.18 a | 30.80 ± 0.26 a | 13.74 ± 0.66 a | 78.14 ± 0.33 c |
| PAM2 | 70.11 ± 0.64 b | 13.57 ± 0.36 c | 31.91 ± 0.51 b | 11.61 ± 0.21 b | 74.83 ± 0.74 a |
| PAM3 | 56.32 ± 0.67 a | 25.24 ± 0.77 b | 33.47 ± 0.56 c | 10.27 ± 0.46 c | 70.64 ± 0.58 b |
| PANM1 | 82.06 ± 0.82 a | 3.86 ± 0.29 a | 2.93 ± 0.22 b | 29.47 ± 0.55 d | 85.76 ± 0.24 a |
| PANM2 | 82.06 ± 0.82 a | 3.86 ± 0.29 a | 2.93 ± 0.22 b | 29.47 ± 0.55 d | 85.76 ± 0.24 a |
| PANM3 | 82.06 ± 0.82 a | 3.86 ± 0.29 a | 2.93 ± 0.22 b | 29.47 ± 0.55 d | 85.76 ± 0.24 a |
| Number | WVP (g/(m2·24 h)) |
|---|---|
| P | 62.68 ± 2.59 a |
| PA1 | 60.80 ± 1.82 a,b |
| PA2 | 60.29 ± 1.97 a,b |
| PA3 | 60.30 ± 1.91 a,b |
| PAM1 | 52.81 ± 2.31 c |
| PAM2 | 55.00 ± 3.32 b,c |
| PAM3 | 55.58 ± 6.04 a,b,c |
| PANM1 | 60.85 ± 1.70 a,b |
| PANM2 | 61.97 ± 4.63 a,b |
| PANM3 | 60.85 ± 3.77 a,b |
| Number | Water Content/% | Dissolution Rate/% |
|---|---|---|
| P | 6.47 ± 0.93 a | 150.83 ± 0.42 a |
| PA1 | 4.30 ± 0.73 b | 147.60 ± 0.29 b |
| PA2 | 4.34 ± 0.55 b | 145.10 ± 0.34 b,c |
| PA3 | 4.10 ± 0.47 b | 143.70 ± 0.50 b,c,d |
| PAM1 | 4.13 ± 0.24 b | 138.40 ± 0.25 d,e,f |
| PAM2 | 4.23 ± 0.44 b | 136.90 ± 0.21 e,f |
| PAM3 | 4.59 ± 1.02 b | 132.80 ± 0.52 f |
| PANM1 | 4.26 ± 0.48 b | 141.90 ± 0.22 b,c,d,e |
| PANM2 | 4.24 ± 0.53 b | 142.40 ± 0.31 b,c,d,e |
| PANM3 | 4.45 ± 0.36 b | 140.70 ± 0.08 c,d,e |
| Number | Specific Migration (mg/kg) |
|---|---|
| PA2 | 0.25 ± 0.03 |
| PAM2 | 0.19 ± 0.04 |
| PANM2 | 0.074 ± 0.29 |
| Cell | Subject (A/B) | Eint (kcal/mol) | Elec in Eint (kcal/mol) | vdW in Eint (kcal/mol) |
|---|---|---|---|---|
| PA | Ag/polymer | −111.80 | 0.0000 | −108.48 |
| PAM | Ag/polymer | −134.47 | 0.0000 | −131.37 |
| PAM | Ag/MMT | −1.61 | 0.0000 | −1.48 |
| PAM | Ag/(polymer + MMT) | −133.73 | 0.0000 | −130.42 |
| PANM | Ag+/polymer | −604.01 | −525.02 | −75.94 |
| PANM | Ag+/MMT | −791.15 | −790.86 | −0.12 |
| PANM | Ag+/(polymer + MMT) | −1498.56 | −1415.96 | −79.30 |
Disclaimer/Publisher’s Note: The statements, opinions and data contained in all publications are solely those of the individual author(s) and contributor(s) and not of MDPI and/or the editor(s). MDPI and/or the editor(s) disclaim responsibility for any injury to people or property resulting from any ideas, methods, instructions or products referred to in the content. |
© 2025 by the authors. Licensee MDPI, Basel, Switzerland. This article is an open access article distributed under the terms and conditions of the Creative Commons Attribution (CC BY) license (https://creativecommons.org/licenses/by/4.0/).
Share and Cite
Yu, W.; Lei, Q.; Jiang, J.; Yan, J.; Yi, X.; Cheng, J.; Ou, S.; Yin, W.; Li, Z.; Liao, Y. Green-Synthesized Silver Nanoparticle-Loaded Antimicrobial Films: Preparation, Characterization, and Food Preservation. Foods 2025, 14, 2509. https://doi.org/10.3390/foods14142509
Yu W, Lei Q, Jiang J, Yan J, Yi X, Cheng J, Ou S, Yin W, Li Z, Liao Y. Green-Synthesized Silver Nanoparticle-Loaded Antimicrobial Films: Preparation, Characterization, and Food Preservation. Foods. 2025; 14(14):2509. https://doi.org/10.3390/foods14142509
Chicago/Turabian StyleYu, Wenxi, Qin Lei, Jingxian Jiang, Jianwei Yan, Xijian Yi, Juan Cheng, Siyu Ou, Wenjia Yin, Ziyan Li, and Yuru Liao. 2025. "Green-Synthesized Silver Nanoparticle-Loaded Antimicrobial Films: Preparation, Characterization, and Food Preservation" Foods 14, no. 14: 2509. https://doi.org/10.3390/foods14142509
APA StyleYu, W., Lei, Q., Jiang, J., Yan, J., Yi, X., Cheng, J., Ou, S., Yin, W., Li, Z., & Liao, Y. (2025). Green-Synthesized Silver Nanoparticle-Loaded Antimicrobial Films: Preparation, Characterization, and Food Preservation. Foods, 14(14), 2509. https://doi.org/10.3390/foods14142509
